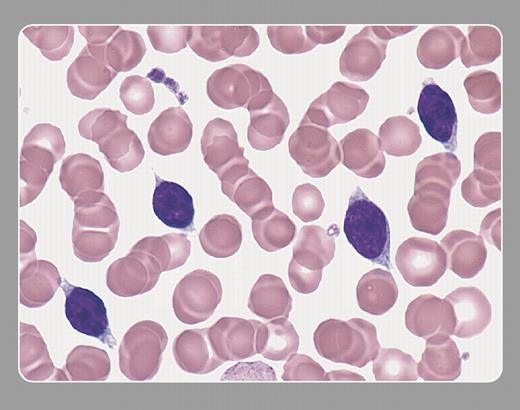
Peter Maslak, Sloan-Kettering Cancer Center

Splenic marginal-zone lymphoma with villous lymphocytes. Villous lymphocytes circulating in the peripheral blood are a characteristic finding in this disorder. These cells have an oval nucleus with the “cobblestone” pattern of nuclear chromatin typical of more mature lymphoid cells. The cytoplasmic projections, or villi, are found in a polar distribution. Villous lymphocytes may be mistaken for hairy cells. However, the cytoplasmic projections in hairy cells have a more even distribution around the circumference of the cell.
Many Blood Work images are provided by the ASH IMAGE BANK, a reference and teaching tool that is continually updated with new atlas images and images of case studies. For more information or to contribute to the Image Bank, visit www.ashimagebank.org.
This feature is available to Subscribers Only
Sign In or Create an Account Close Modal